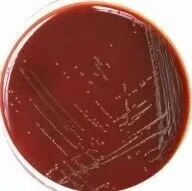

目前靠谱的配资公司,我国对流行性脑脊髓膜炎(简称“流脑”)有着非常积极的预防策略。在常规的接种计划中,孩子们都会接种针对A群和C群的疫苗。
但家长们可能会发现,现在的疫苗种类越来越多,名字里的字母也越来越长。为什么要盯着这些字母看?这就要从流脑细菌——脑膜炎奈瑟菌(流脑细菌)那高超的“变装术”说起。它就像一个潜伏在暗处的“职业刺客”,起病快、下手狠。要战胜它,我们必须拆穿它的伪装。
实验室培养皿上的脑膜炎奈瑟菌
一、不同的字母,
不同的“外套”
流脑细菌之所以有好几种身份(也就是医生说的“血清群”),秘密全在它穿的那层“糖衣外套”上。
在细菌内部,有一个专门生产外套的“全自动工厂”(cps基因簇)。它会根据不同的“生产图纸”(遗传信息),像搭积木一样,把原料组装成不同“款式”的外套。这些外套的“款式”,就是我们看到的A、B、C、W、X、Y等不同代号。

二、狡猾的“变色龙”:
如何躲过安检
在全球范围内,约95%的病例是由这六种“款式”的细菌引起的。它们之所以难缠,存在抗体和病原菌两方面的原因:
抗体只认衣服不认人
疫苗接种后产生的抗体,就像是小区门口“认衣不认脸”的保安。如果你只接种了“A款”疫苗,保安手里就只有“A款”的照片。当穿着“C款”外套的细菌潜入时,保安就会因为“没见过这种衣服”无法识别“敌人”而放它通行,导致防线失守。

病原菌“金蝉脱壳”
流脑细菌非常聪明,它不仅会自我进化,还会偷偷学习其他细菌的“穿搭指南”。它能修改自己的“工厂图纸”,在短时间内把外套从“A款”换成“C款”。这种“分子级别的换装”让它能反复躲避抗体的围剿。

三、给孩子的“防弹衣”怎么选
面对这位随时可能“换装”的刺客,家长们不必焦虑。我国的疫苗接种策略已经为孩子们准备了多层的防护体系。在选择这件“防弹衣”时,我们可以参考以下三个锦囊:
免疫规划疫苗能提供重要保护
我国已经将流脑疫苗纳入免疫规划。孩子们在出生后,可以按照国家免疫程序免费接种A群流脑多糖疫苗和A群C群流脑多糖疫苗。这就像是为孩子穿上了一件抵御最常见“刺客款式”的基础款防弹衣,能够有效拦截目前最主要的威胁。
其他方案也是有益补充
如果你希望防护网能网罗更多的“变装款式”,可以选择非免疫规划疫苗(自费)作为补充或替代。比如四价流脑结合疫苗(ACYW135群),它不仅涵盖了基础款,还能同时防御W、Y等其他潜在群别。无论细菌的外套怎么变,只要我们的“识别图谱”足够宽,就能让“刺客”无处遁形。
尽早给孩子“穿上”防弹衣
流脑的高风险期通常在孩子6个月到2岁之间。对于免疫系统尚未发育成熟的婴幼儿,“结合疫苗”是更先进的选择,它能让孩子的免疫细胞产生更深刻、更持久的记忆。/健康科普
作者:传染病所 徐丽、王海瑞、乔耘川
审核:阚飙
编辑:杨紫萱、张林林
监制:姚建义、于子涵靠谱的配资公司
旺源配资提示:文章来自网络,不代表本站观点。